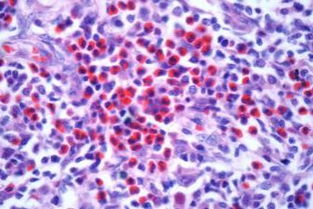
T细胞和效应T细胞分泌的淋巴因子各自有什么作用?

淋巴细胞借助淋巴因子对邻近或远离的靶细胞产生作用,这与抗体的作用相平行,是实现免疫效应和免疫调节功能十分重要的途径。
淋巴因子是淋巴细胞的产物,用于细胞免疫的各种体外检查方法中,进行免疫诊断。
淋巴因子的各种生物学活性。
淋巴因子在细胞免疫中的作用主要体现在:不同的淋巴因子能表现多种生物学活性,可作用于相应的靶细胞,使靶细胞发生特性或功能的变化。
淋巴细胞借助淋巴因子对邻近或远离的靶细胞产生作用,这与抗体的作用相平行,是实现免疫效。

效应t细胞能产生淋巴因子的作用主要是为了增强免疫。
解析:在细胞免疫的效应阶段,效应T细胞分泌淋巴因子。
淋巴因子可以增强免疫细胞的功能。
例如,干扰素是一种效应T细胞释放的淋巴因子,能抑制病毒增殖,保护细胞不受病毒感染。
最终使免疫效应扩大和增强,呈递抗原信息。
效应T细胞:释放淋巴因子大多通过加强各种有关细胞的作用来发挥免疫效应。
例如,白细胞介素-2能诱导产生更多的效应T细胞,并且增强效应T细胞的杀伤力。
理解的有没有偏差。
细胞免疫中,淋巴因子的作用是增强效应T细胞的杀伤力。
体液免疫中,淋巴因子能促进B细胞的增殖和分化。